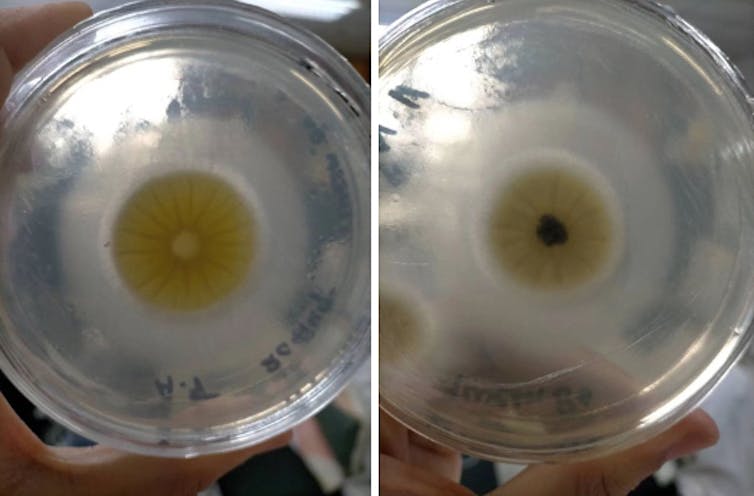

Delante del colegio de mis hijos hay un contenedor de aceite usado. Uno de esos contenedores en los que tiramos el aceite de cocinar una vez inservible. Quién iba a pensar que en uno de esos contenedores yacía una de las soluciones a los vertidos como el del Prestige, que hace ahora 20 años cubrió de chapapote muchas playas del norte de España.
Llevo años trabajando con el grupo de la profesora Ying Han, de la Universidad de Ciencia y Tecnología del Suroeste (China), en cuestiones relacionadas con la biorremediación. Esto es, en cómo usar diferentes plantas y microbios para limpiar la contaminación de los suelos. En nuestro último estudio, publicado recientemente, presentamos un nuevo método para limpiar las playas de vertidos accidentales de diésel. Y para ello utilizamos unos hongos que crecen, precisamente, en los contenedores de aceite.
El reto: alta salinidad e hidrocarburos complejos
Actualmente disponemos de diferentes tratamientos manuales, químicos y térmicos para remediar los vertidos de hidrocarburos de petróleo. Se trata de procedimientos caros y que, en ocasiones, pueden conllevar efectos adversos sobre el medio.
La biorremediación, en cambio, es una técnica natural, de bajo coste y que suele carecer de efectos adversos. Esta técnica lleva décadas siendo aplicada para limpiar los vertidos de petróleo y derivados. Estudios anteriores han mostrado una gran eficiencia en ausencia de sales. Sin embargo, la eficacia de este tratamiento es baja en ambientes salinos como los de la costa. Esto es porque los organismos que degradan los derivados del petróleo se deshidratan por la sal
La biorremediación presenta otro problema: su eficacia disminuye en hidrocarburos complejos. Hasta ahora, solo se había logrado degradar rápidamente compuestos sencillos, como los fenoles, en ambientes salinos. El vertido del Prestige, sin embargo, estaba compuesto por una mezcla de hidrocarburos saturados, aromáticos y resinas. Estos hidrocarburos resultan mucho más difíciles de degradar que los fenoles.
El procedimiento: hurgar en los contenedores
Necesitábamos por tanto encontrar algún tipo de microbio que fuera capaz de degradar hidrocarburos complejos en ambientes salinos. Los estudios anteriores se habían centrado en bacterias, pero documentaron unas tasas de degradación lentas e incompletas. Una vez descartadas las bacterias, nos decidimos por explorar el potencial de los hongos.
Buscamos a nuestros candidatos entre los hongos que crecían en los contenedores de aceite usado. Los cultivamos en placas de Petri en el laboratorio donde los expusimos a diferentes concentraciones de sal y de diésel. Ahí observamos cómo, al cabo de un tiempo, el diésel había desaparecido: se lo habían “comido” los hongos.
Identificación de los hongos
Habíamos encontrado unos hongos que degradaban los hidrocarburos. Pero eso no resolvía del todo el problema. Quedaba por saber quiénes eran esos organismos, cómo degradaban los hidrocarburos y qué efectos iban a ejercer sobre el suelo y sobre el resto de microbios.
Para determinar la identidad de los hongos secuenciamos parte del genoma e identificamos dos líneas diferentes de hongos del género Aspergillus. En particular, la estructura genética se parecía mucho a Aspergillus niger.
Aspergillus niger es un viejo conocido de la industria alimentaria. Es muy común encontrarlo en salsas, vinos y vinagres, por lo que no suele representar ningún peligro para la salud. Esta especie también se usa para fermentar azúcares en la fabricación del ácido cítrico o glucónico. Hay otros hongos del género Aspergillus, tales como Aspergillus flavus, que son tóxicos y nocivos para la salud humana, pero no es el caso de Aspergillus niger.
Vimos que la degradación de hidrocarburos era más efectiva cuando juntábamos ambas líneas de Aspergillus ya que, a pesar de su similitud genética, existen diferencias en su metabolismo. Aspergillus niger usa los hidrocarburos como fuente de carbono. Esto es, come petróleo. Y lo hace segregando unas enzimas, las lipasas y lacasas, que catalizan la degradación. También empleamos hematita, un mineral compuesto de óxido férrico, que aceleró la degradación al aportar electrones para la oxidación del diésel.
Otro resultado interesante fue que la aplicación fúngica alteraba la comunidad microbiana. En particular, comprobamos que aumentaba la presencia de otros hongos que también degradan hidrocarburos. Es decir, se estableció una especie de reacción en cadena donde el uso de Aspergillus fomentó la presencia de otras especies que aceleraban la degradación del diésel.
Aplicación práctica
La aplicación práctica de esta técnica es sencilla. Se pueden esparcir los hongos mezclados con agua a través de aerosoles o esprays, o se pueden inocular directamente en el suelo. Para su empleo a gran escala, los aerosoles son más prácticos. Tras la aplicación, solo hay que esperar.
Este trabajo forma parte de la tesis doctoral de Sumbal Sajid, también de la Universidad de Ciencia y Tecnología del Suroeste, y los resultados son más que prometedores: al cabo de 50 días, la concentración de diésel había disminuido un 88 %. Se trata del mejor resultado en lo que se refiere a la cantidad y rapidez de limpieza hasta la fecha.
Resulta evidente que la mejor forma de prevenir un desastre tras el vertido de hidrocarburos de petróleo es evitando que ocurra dicho vertido y, sobre todo, abandonando el uso de combustibles fósiles. Pero mientras eso no sea posible, esta nueva técnica de biorremediación puede acelerar el proceso de recuperación.
No hay comentarios:
Publicar un comentario